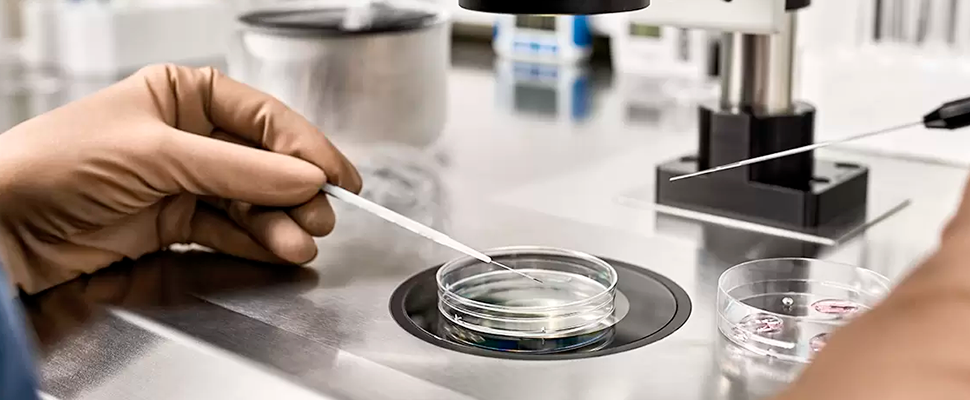

Atendimento exclusivo Ingámed/Inveq
onlineOlá, para que possamos iniciar uma conversa, por favor, preencha os dados abaixo.
aguarde.
Olá, fale com uma de nossas consultoras! Nosso time está pronto para atender você.
Tecnologia em Reprodução Assistida

Na rotina de laboratórios especializados em reprodução assistida, o sucesso da fertilização in vitro (FIV) depende de diversos fatores, muitos dos quais são invisíveis a olho nu — mas absolutamente determinantes. Entre eles, os meios de cultura para FIV exercem um papel fundamental na manutenção da viabilidade, no desenvolvimento embrionário e na segurança microbiológica de todo o processo.
Neste artigo, explicamos o que são esses meios, quais os principais tipos, como escolhê-los adequadamente e as boas práticas de armazenamento e manuseio. Um conteúdo essencial para embriologistas, biomédicos e gestores de laboratórios que buscam resultados superiores e máxima segurança nos procedimentos.

Os meios de cultura para reprodução humana são soluções cuidadosamente formuladas para simular o ambiente ideal ao qual os gametas e embriões estariam expostos no organismo materno. Eles oferecem suporte nutricional, controle de pH e osmolaridade, além de atuarem como barreira protetora contra agentes externos.
Na prática, os meios atuam em todas as fases da FIV:
Cada etapa requer um tipo de meio específico, com formulações ajustadas para maximizar as taxas de sucesso e minimizar riscos.

A seguir, os tipos de meios de cultura mais comumente utilizados em procedimentos de fertilização assistida:
A escolha de meios de cultura impacta diretamente os índices de sucesso dos ciclos de FIV. Por isso, é fundamental considerar os seguintes critérios:
A análise de microrganismos contaminantes também deve ser realizada regularmente para garantir a pureza dos meios e proteger os embriões em cultivo.

Para manter a eficácia dos meios de cultura para fertilidade, é indispensável seguir protocolos rígidos de conservação:
Essas medidas aumentam a confiabilidade dos resultados e reduzem riscos laboratoriais.

A Ingámed oferece uma linha completa e tecnicamente validada de meios de cultura para reprodução assistida, desenvolvida com foco na segurança, estabilidade e desempenho clínico. Nossos produtos atendem às exigências dos principais centros de reprodução humana, com:
Com décadas de experiência no fornecimento de soluções para laboratórios, a Ingámed se posiciona como parceira estratégica para clínicas e profissionais que não abrem mão de precisão e segurança em reprodução assistida.
Mais do que insumos, os meios de cultura para FIV representam a base sobre a qual se constroem as taxas de sucesso dos tratamentos. Sua escolha cuidadosa, aliada a práticas de armazenamento e manuseio seguros, é essencial para garantir o desenvolvimento embrionário saudável e a confiabilidade dos processos laboratoriais.
Se você busca meios de cultura para reprodução humana com desempenho comprovado e suporte especializado, conheça a linha da Ingámed. Fale com nossos consultores e eleve o padrão do seu laboratório.